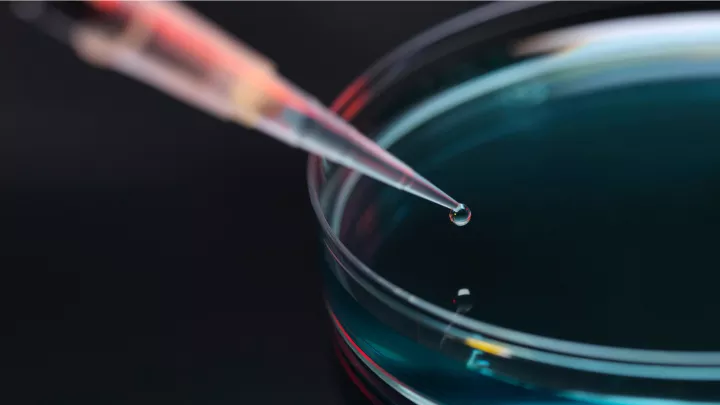
A pipette deposits a drop of liquid into a petri dish against a dark background.

Our Sickle Cell Disease Research Initiatives
Our dedicated team has pioneered efforts to advance the understanding and treatment of sickle cell disease, unlocking new insights and innovative therapies. Montefiore Einstein was one of the first contributors to epigenetics, and we continue to investigate sickle cell disease through genetic mapping, microvascular studies and multifaceted research initiatives.
By working with our colleagues at the Center for Health Data Innovations, we’ve contributed to the longitudinal assessment of lifespan challenges associated with sickle cell disease, including monitoring transition patients for successful transition data. Our participation in data hubs allows us to incorporate machine learning into our algorithms to optimize delivery of care and to implement evidence-based pain protocols to standardize care. We have also been involved in Hemoglobin F inducer protocols, sponsored by pharmaceutical partners.
We are actively investigating new treatments for sickle cell disease, including gene therapy and partial-match bone marrow transplantation, as well as new approaches to treat the effects of this disease. Through a commitment to excellence in both research and patient care, we’ve made significant strides in enhancing the quality of life for individuals affected by sickle cell disease with the ultimate goal of finding new cures.

Video could not be played

Video could not be played
Sickle Cell Disease Gene Therapy Certified Treatment Center
We are one of the few gene therapy certified treatment centers for sickle cell disease in the country. Gene therapy is an FDA-approved treatment that has been shown to cure sickle cell disease by correcting or replacing the gene responsible for producing abnormal hemoglobin. For eligible patients affected by the condition, this innovative approach holds hope for providing a long-term cure and improving their quality of life.